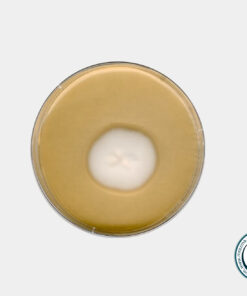
محیط کشت سابرود دکستروز آگار مرک SDA کد 105438\ فروشگاه اینترنتی مستر آزما

سابرو دکستروز آگار مرک
سابرود دکستروز آگار مرک یا SDA یک محیط کشت انتخابی است. این محیط pH اسیدی این محیط از رشد باکتری ها جلوگیری می کند و امکان رشد مخمر ها و قارچ های رشته ای را فراهم می کند. فروش و قیمت محیط کشت سابرو دکستروز آگار مرک در فروشگاه مواد شیمیایی/ آزمایشگاهی مسترآزما فقط در حجم های شرکت سازنده (مرک آلمان) امکان پذیر است.
کاربردهای سابرود دکستروز آگار مرک
- برای جداسازی درماتوفیت ها
- جداسازی قارچ ها
- جداسازی مخمر ها و باکتری ها
- جهت رشد مخمرها و قارچ های رشته ای
- استفاده در صنایع غذایی
- صنایع تولید محصولات آرایشی
مواد تشکیل دهنده محیط کشت سابرو دکستروز
- دکستروز
- پپتون
- آگار
فروش سابرود دکستروز آگار مرک کد 105438
فروشگاه مستر آزما به عنوان یکی از تامین کنندگان پیشگام محصولات شیمیایی و محیط های کشت از معتبرترین برندهای جهان آماده تامین و عرضه محیط کشت با کد 105438 با کیفیتی عالی و قیمتی رقابتی در مقادیر مختلف از کمپانی معتبر شرکت مرک – سیگما آلمان می باشد.
این کالا به همراه برگه آنالیز و ضمانت اصالت کالا به فروش می رسد.

دیدگاهها
هیچ دیدگاهی برای این محصول نوشته نشده است.